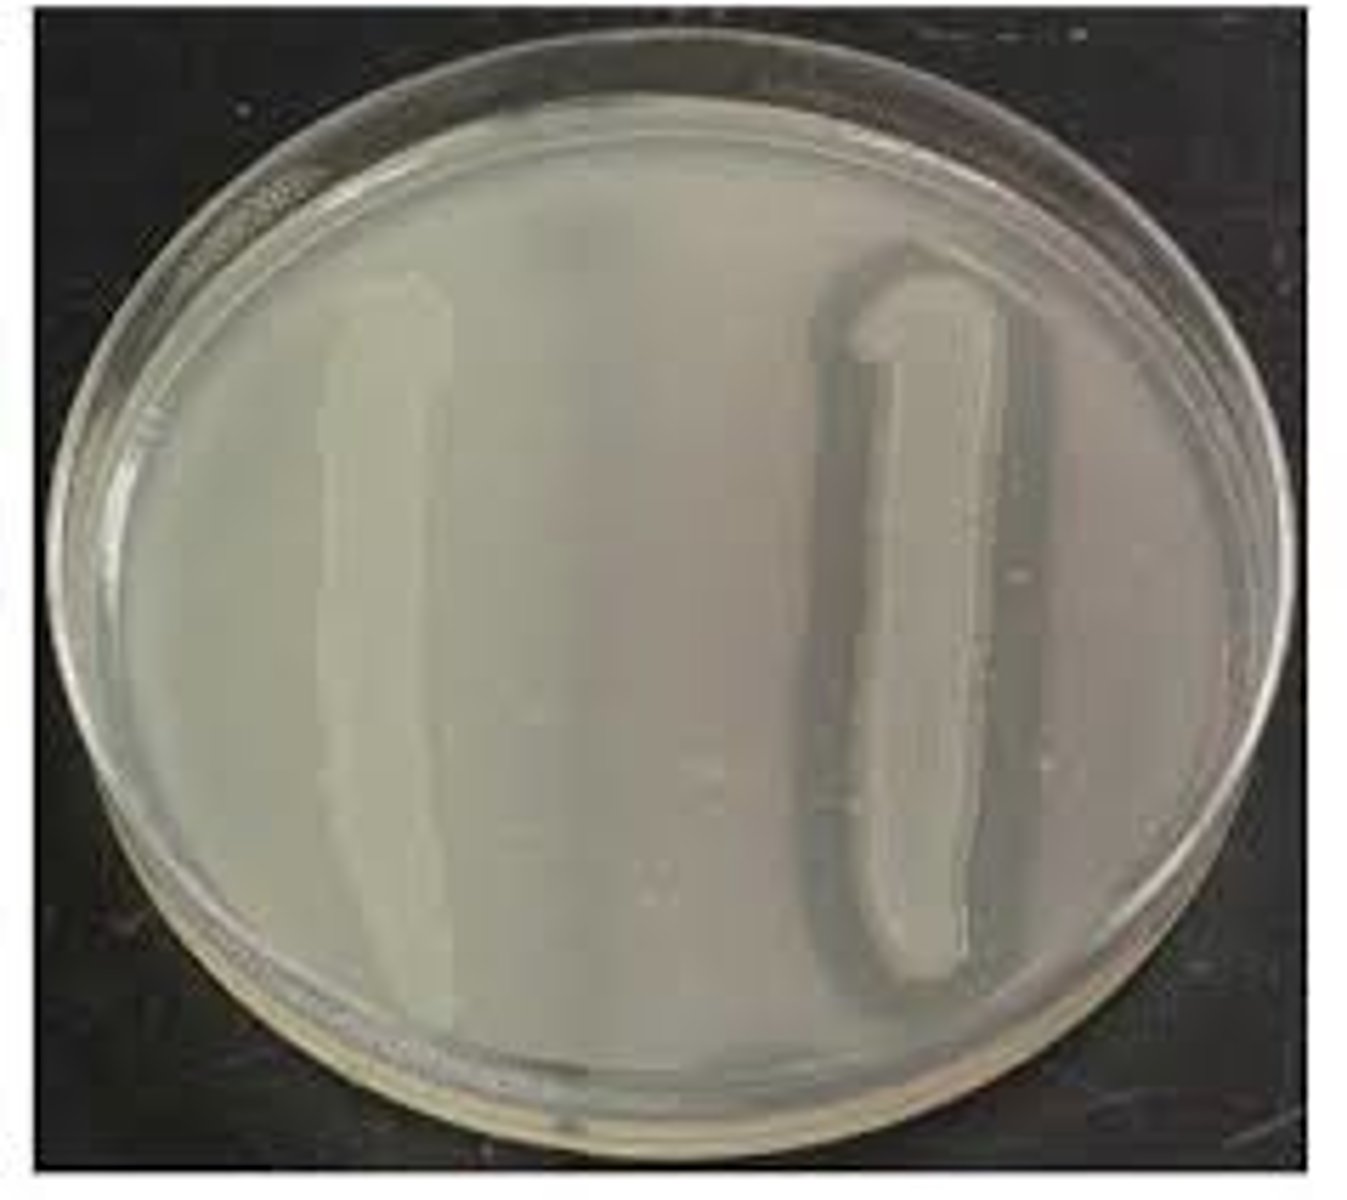
<p>What bacterial enzyme is produced by the organism on the right, distinguished by the clear area around its growth on skim milk agar?</p>

BI 127 Lab #20: Biochemical Tests 2
1/15
There's no tags or description
Looks like no tags are added yet.
Name | Mastery | Learn | Test | Matching | Spaced | Call with Kai |
|---|
No analytics yet
Send a link to your students to track their progress
16 Terms
Gram's iodine
When testing for starch hydrolysis, what reagent is used on the starch agar plate?
Black or dark purple
When starch is combined with Gram's iodine, what color does it turn?
1
When performing the starch hydrolysis test, what will the medium look like if the bacteria breaks down starch?
1. Clear area around the growth
2. Red
3. Bubbles will form
4. Pale pink
Small polypeptides and amino acids
In the casein hydrolysis test, the enzyme casease breaks down casein into what?
Clear area around bacterial growth
What does a medium look like when casein hydrolysis has occurred?
4
In gelatin hydrolysis, the enzyme gelatinase breaks gelatin down into what?
1. Pyruvate and urea
2. Carbon dioxide and acid
3. Carbohydrates
4. Small polypeptides and amino acids
The medium is liquid
You are performing the gelatin hydrolysis test. After inoculation, incubation and refrigeration, how can you tell if a bacterium produces the enzyme gelatinase?
Bright pink
You are performing the urea hydrolysis test. What color does the solution turn if a bacterium breaks down urea?
Carbon dioxide and ammonia
When a bacterium hydrolyzes urea, what byproducts are produced?
Black precipitate
If a bacterium has the enzyme cysteine desulfurase, it can convert cysteine into hydrogen sulfide. What will you see in the medium if this happens?
Casease
What bacterial enzyme is produced by the organism on the right, distinguished by the clear area around its growth on skim milk agar?
Stab with an inoculating needle
How do you inoculate a peptone iron agar deep to test for hydrogen sulfide production?
2
The breakdown of milk protein by the enzyme casease produces which of the following?
1. Starches
2. Amino Acids
3. Lipids
4. Sugars
Glucose
What is the product of Starch agar
Amylase
What enzyme is used to make glucose in starch hydrolysis
Starch Agar, Skim Milk agar, Nutrient Agar Deep, Urea Broth, Peptone Iron Agar Deep
Starch hydrolysis, Casein hydrolysis, Gelatin hydrolysis, Urea hydrolysis, Hydrogen sulfide production